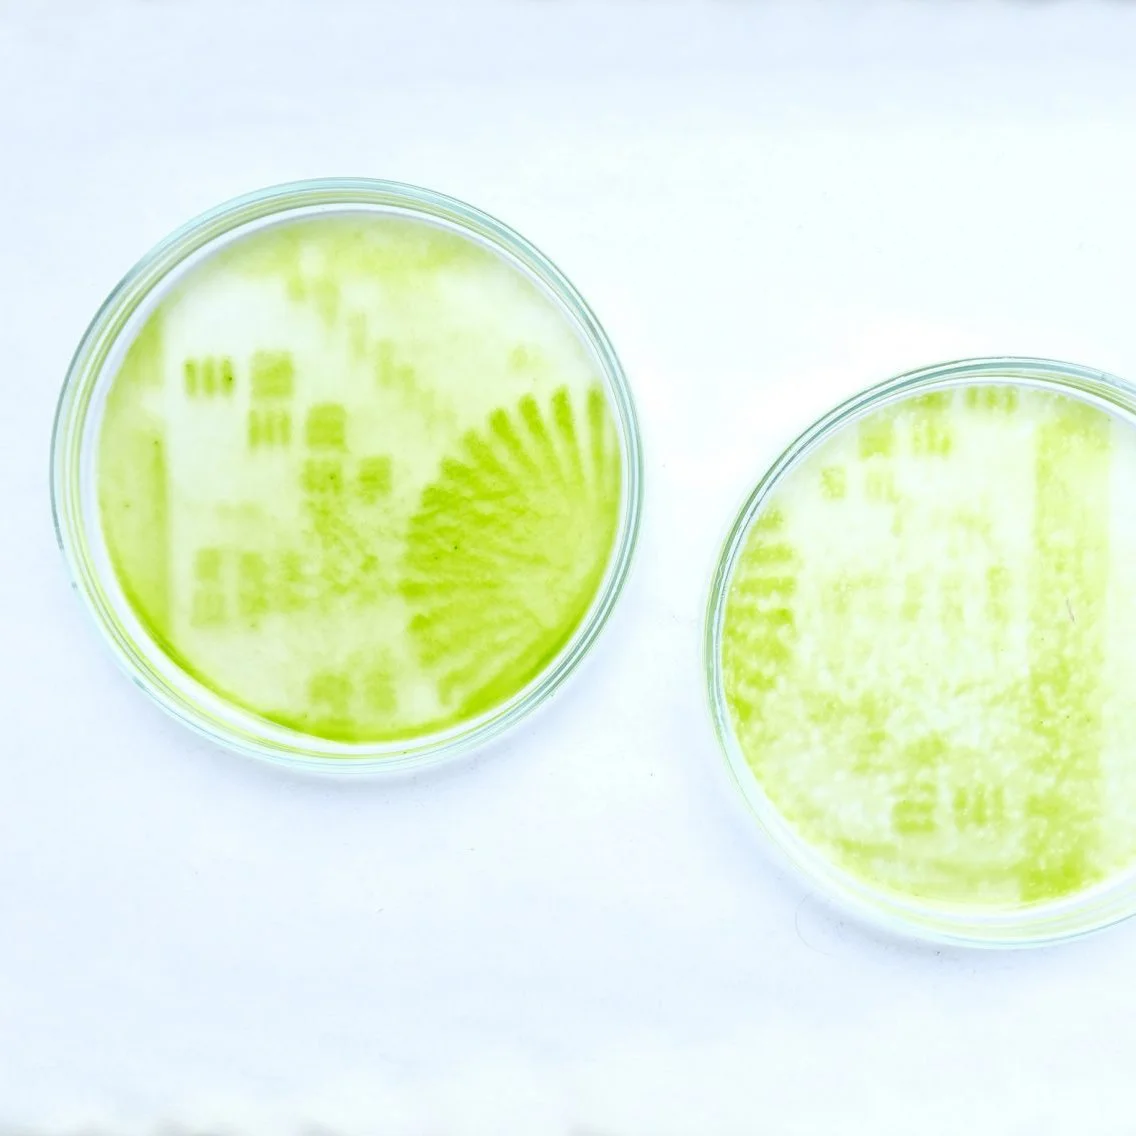

Chlorophyllia
In praise of plants
Primal need
It’s always been said that people are green-thumbed or they are not. But the successive lock downs made a lot of people realize how relaxing and rewarding it is to take care of plants. In general, the covid situation made us recognize our primal need for green. Here we were, rushing to the countryside, braving Covid restrictions for a walk in the park and filling our flats with houseplants.
Our relationship with plants and nature is primal. But despite this fact, we grew so far away from this link. Hopefully, the current climate concerns will push us to reconnect with our chlorophyllian friends and their ways. And even if we don’t manage in time, we might be doomed but plants will always find a way to survive because of their power of resilience and their evolutionary skills. They are much more remarquable than we realize.
“Plants are the key to the future of our planet.”
Carlos Magdalena, Botanical Horticulturist at Kew Gardens
Unknown potential
Plants are the basis of everything around us. They provide the air we breathe, our clothes, our food, our medicine and shelter.
But more than that, their genetics and the way they evolve is absolutely fascinating and sometimes seems to defy science. Did you know that plants can develop memory ? They are basically able to live forever thanks to their high adaptability. Their own genes evolve during their lifetime and the last leaf that grows doesn't have the same genome as the first one.
I am always surprised that technology, science and even design never got more inspired by plants when they have so much to offer. But maybe it’s not too late ?
The future will be green
Plants are the past, the present but mainly the future. Our only way to survive is to ally our knowledge and technology to their qualities. We need to do it with a deep respect for what nature has to offer.
Let’s make plants our best allies when everything goes wrong. They are our only way out. Some designers started to understand that and to experiment with plant's properties. They found new ways we can work together with them: growing edible algaes at home, growing your own shoes...
Merging plants and technology, nature and knowledge, respect and open mindness, is the future.
Dreaming of symbiosis
I have always had this dream of a hybrid human / plant. Think about it, this would make us reach what we've always dreamed for : immortality. The only thing we would have to do is to slow down and simply grow forever. We would be autonomous making our own oxygen and feeding from our own CO2. Be in constant evolution and make one with Nature. I really wish one day I could turn green and do photosynthesis.
What could that ultimate collaboration between plants and humans look like ?
NEW MATERIALS
The use of algae seems to be one of the best way of using the properties of plants in designs and materials.
Indus Tiles
Algae infused tiles by the Bio-Integrated Design Lab at the Bartlett School of Architecture to clean polluted air.
Bioplastic Sequins
Algae based sequins by Fashion designer Phillip Lim together with industrial designer Charlotte McCurdy for OneXOne project.
Algae Palette
A collection of textile prints dyed with extracted colours from macro algae species by Tahiya Hossain.
Biogarmentry
Clothes made from algae that turn carbon dioxide into oxygen via photosynthesis by designer Roya Aghighi.
COLOUR PALETTE
A vibrant colour palette expressing the fusion between plants, science and technology.
INSPIRATIONS
READING
“In Praise of Plants”, book written by Francis Hallé
EXHIBITION
Plant fever exhibition: www.plantfever.com
TV SERIES
Biohackers, german series by Christian Ditter on Netflix
MAGAZINE
Next Nature Magazine : www.nextnature.net
READ MORE
Natalia Tryantafylli
HIGHLIGHT_
Interview with an inspiring young designer proposing a new gaze on city heritage.
March 2022
Styled by Night
HIGHLIGHT_
The marvelous world of Iona Thomas.
November 2021